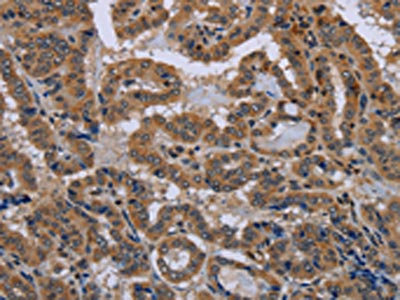

NPHS2 Antibody
-
中文名稱:NPHS2兔多克隆抗體
-
貨號(hào):CSB-PA579527
-
規(guī)格:¥1100
-
圖片:
-
The image on the left is immunohistochemistry of paraffin-embedded Human thyroid cancer tissue using CSB-PA579527(NPHS2 Antibody) at dilution 1/40, on the right is treated with synthetic peptide. (Original magnification: ×200)
-
Gel: 10%SDS-PAGE, Lysate: 40 μg, Lane: Human hepatocellular carcinoma tissue, Primary antibody: CSB-PA579527(NPHS2 Antibody) at dilution 1/200, Secondary antibody: Goat anti rabbit IgG at 1/8000 dilution, Exposure time: 2 minutes
-
-
其他:
產(chǎn)品詳情
-
Uniprot No.:
-
基因名:NPHS2
-
別名:nephrosis 2 antibody; Nephrosis 2, idiopathic, steroid resistant (podocin) antibody; nephrosis 2, idiopathic, steroid resistant antibody; NPHS2 antibody; NPHS2 gene antibody; PDCN antibody; PODO_HUMAN antibody; Podocin antibody; SRN1 antibody
-
宿主:Rabbit
-
反應(yīng)種屬:Human,Mouse,Rat
-
免疫原:Synthetic peptide of Human NPHS2
-
免疫原種屬:Homo sapiens (Human)
-
標(biāo)記方式:Non-conjugated
-
抗體亞型:IgG
-
純化方式:Antigen affinity purification
-
濃度:It differs from different batches. Please contact us to confirm it.
-
保存緩沖液:-20°C, pH7.4 PBS, 0.05% NaN3, 40% Glycerol
-
產(chǎn)品提供形式:Liquid
-
應(yīng)用范圍:ELISA,WB,IHC
-
推薦稀釋比:
Application Recommended Dilution ELISA 1:2000-1:5000 WB 1:200-1:1000 IHC 1:50-1:200 -
Protocols:
-
儲(chǔ)存條件:Upon receipt, store at -20°C or -80°C. Avoid repeated freeze.
-
貨期:Basically, we can dispatch the products out in 1-3 working days after receiving your orders. Delivery time maybe differs from different purchasing way or location, please kindly consult your local distributors for specific delivery time.
-
用途:For Research Use Only. Not for use in diagnostic or therapeutic procedures.
相關(guān)產(chǎn)品
靶點(diǎn)詳情
-
功能:Plays a role in the regulation of glomerular permeability, acting probably as a linker between the plasma membrane and the cytoskeleton.
-
基因功能參考文獻(xiàn):
- In conclusion, the authors identified SNX9 as a facilitator of podocin endocytosis in severe podocyte injury and demonstrated the expression of SNX9 in the podocytes of both nephropathy model mice and human patients with irreversible glomerular disease. PMID: 28266622
- Mutations of NPHS2 gene are common among Egyptian children with Steroid-resistant nephrotic syndrome. PMID: 28385484
- C-terminal oligomerization of podocin can mediate both a dominant negative effect and interallelic complementation. Interallelic interactions of NPHS2 are not restricted to the R229Q variant and have to be considered in compound heterozygous individuals. PMID: 29660491
- Heterozygous deletion in the NPHS2 gene involved in familial steroid-resistant nephrotic syndrome with early onset, slow progression and dominant inheritance pattern. PMID: 27573339
- polymorphisms predicted in this study might be disease causing in the NPHS2 gene and may have influence on the therapeutic response of nephrotic syndrome patients PMID: 28712774
- Mutations in podocin alter the innate intraprotein interactions affecting the native structure of podocin and its ability to form critical complex with subpodocyte proteins PMID: 27193387
- NPHS2 mutations/SNPs serve as important molecular markers in treating children with early stage idiopathic nephrotic syndrome. PMID: 26820844
- Two siblings with CRB2 -related syndrome were both heterozygous for a variant in NPHS2. PMID: 27004616
- This study shows that p.R229Q and p.A284V are the most frequent variants in Chilean children with steroid resistant nephrotic syndrome; it is the first time that this relationship has been reported in Chilean children PMID: 26455708
- Ubiquitin ligase Ubr4 is a key component of the podocin interactome purified from podocytes. Ubiquitylation of one podocin site, K301, do not only target podocin for proteasomal degradation, but may also affect stability and disassembly of the multimeric complex. PMID: 26792178
- Oligoallelic amino acid mutations in podocin may be potential causative mutations for proteinuria (meta-analysis) PMID: 26211502
- The results support the hypothesis that certain hypomorphic podocin variants may act as adverse genetic modifiers when co-inherited with COL4A3 mutations PMID: 26138234
- translocation of podocin by endocytosis could be a key traffic event of critical podocyte injury and that the podocin gap could indicate the prognosis of IgA nephropathy. PMID: 25676004
- NPHS2 mutations account for only 15% of nephrotic syndrome cases. PMID: 26420286
- NPHS2 rs61747728 variant is not associated with nephrotic syndrome in children. PMID: 25599733
- A single gene is involved in the development of steroid-resistant nephrotic syndrome. PMID: 25349199
- NPHS2 gene mutations are not a major cause of chronic renal insufficiency caused by late SRNS in Chinese southern infants PMID: 25112471
- for adult-onset disease (onset age > 18), the homozygous variant could be a potential predictor of hereditary nephrotic syndrome; the p.R229Q allele cannot currently be considered a risk factor for predicting focal segmental glomerulosclerosis. PMID: 24715228
- Thus, NPHS2 gene showed R229Q polymorphism and patients achieved partial remission to therapy. PMID: 24519673
- Variants in NPHS2, SDCCAG8 and near BMP4 appear to interact with APOL1 to modulate the risk for non-diabetic end stage kidney disease in african americans. PMID: 24157943
- NPHS2 mutations are prevalent in Indian patients with , Idiopathic, steroid-resistant Nephrotic syndrome and this may in part explain the less favourable prognosis reported in these patients. PMID: 24674236
- Four patients had homozygous c.413G>A (p.Arg138Gln) NPHS2 mutations; one subject was homozygous for c.868G>A (p.Val290Met) NPHS2. PMID: 24856380
- Case Report: novel NPHS2 sequence variant in a girl with steroid-resistant nephrotic syndrome and focal and segmental glomerulosclerosis. PMID: 24969201
- the frequency of identified disease causing mutations (NPHS1 and NPHS2) in children with steroid-resistant nephrotic syndome is 11.4%, and they show no response to treatment. PMID: 24413855
- The results suggest that the functions of Nephrin and Podocin are highly conserved between the zebrafish pronephros and mammalian metanephros. PMID: 24337247
- 25 novel pathogenic mutations have been identified in steroid-resistant nephrotic syndrome. They includes missense, nonsense, small insertions, small deletions, splicing, indel mutations, and a mutation in the stop codon. PMID: 24227627
- Mutations of podocin were frequent among south-west Iranian pediatric population with steroid-resistant nephrotic syndrome. PMID: 24072147
- the carboxyl terminus of podocin/MEC-2 has to be placed at the inner leaflet of the plasma membrane to mediate cholesterol binding and contribute to ion channel activity. PMID: 24596097
- The NPHS2 gene p.R229Q polymorphism does not present in an Iranian-Azeri population with late-onset steroid-resistance nephrotic syndrome. PMID: 24072153
- present an autosomal-recessive disorder, nephrotic syndrome type 2 (MIM 600995), in which the pathogenicity of an NPHS2 allele encoding p.Arg229Gln depends on the trans-associated 3' mutation PMID: 24509478
- Focal segmental glomerulosclerosis patients with NPHS2 homozygous p.R229Q should be screened for the causative mutation in a second gene. PMID: 23800802
- The podocin mutation R229Q may play a role in the pathogenesis of focal segmental glomerulosclerosis and in early recurrence after transplantation, but does not allow accurate prediction of recurrence or the associated potential for prevention. PMID: 23982418
- study identified NPHS2 mutations in Mexican children with nephrotic syndrome; Podocin heterozygous missense mutations L139R and L142P were found; the former was found in steroid-sensitive and steroid-resistant children; the latter was found in a steroid-resistant child PMID: 23913389
- analysis of NPHS2 mutations in Polish patients with steroid-resistant nephrotic syndrome reveals a founder effect PMID: 23645318
- A second short isoform of podocin was found to be expressed in the kidney. PMID: 23648087
- an Iranian family of familial steroid-resistant nephrotic syndrome with 3 affected children was reported in which NPHS2 gene has been detected; in exon 4 of the NPHS2 gene, c.503G>A X R168H homozygous mutation was found; both parents of index case were heterozygous carrier with the same mutation compatible with recessive inheritance PMID: 23013956
- Suggest screening for NPHS2 p.R229Q/p.V290M mutations in Central and Eastern European patients with late-onset steroid-resistant nephrotic syndrome. PMID: 23242530
- A total of 7 homozygous (6 novel) mutations were found in the NPHS1 gene and 4 homozygous mutations in the NPHS2 gene. PMID: 22565185
- We examined the frequency and spectrum of podocin NPHS2 mutations in Indian children with sporadic steroid resistant nephrotic syndrome. Of 25 children screened, only one (4%) had a pathogenic mutation resulting in a stop codon. PMID: 22080622
- NPHS2 mutations are rare in patients with adult onset of FSGS/MCD. The R229Q polymorphism is frequent in the Czech population and probably could have some influence on IGAN PMID: 22578956
- NPHS2 polymorphisms were identified in northern Chinese IgA nephropathy patients. The frequencies of NPHS2 T allele and TT/CT genotype were the protective factors for urinary protein. PMID: 22321327
- in patients with familial hematuria, NPHS2-R229Q predisposes to proteinuria and end-stage kidney disease PMID: 22228437
- NPHS2 mutations account for a significant proportion of all nephrotic patients, roughly corresponding to a mutation detection rate of 45-55% in families with recessive traits and 8-20% of sporadic cases. PMID: 22120861
- we are for the first time able to prove the expression of a novel podocin isoform (isoform 2), exclusively and constitutively expressed in human podocytes, and reveal singular extrarenal podocin expression in human and murine testis PMID: 21499232
- Data show that the main slit diaphragm proteins, nephrin and podocin, are affected from the earlier stages of lupus nephritis and their expression correlates with disease histology. PMID: 21478284
- The urinary mRNA profiles of synaptopodin, podocalyxin, CD2-AP, alpha-actin4, and podocin were found to increase with the progression of diabetic nephropathy. PMID: 21655212
- NPHS2 mutation analysis has a clinical value in both childhood- and adult-onset steroid-resistant nephrotic syndrome patients. PMID: 20947785
- Novel mutations in steroid-resistant nephrotic syndrome diagnosed in Tunisian children were detected in NPHS2. PMID: 21125408
- plasmapheresis can result in clinical improvement and stabilization of SRNS caused by podocine mutation. A combined heterozygous form of two NPHS2 gene mutations (p.R138Q and p.V290M) was diagnosed PMID: 21171529
- NPHS2 mutations are not a major cause of familial steroid-resistant nephrotic syndrome in Southern Chinese Han ethnic group. PMID: 19099831
顯示更多
收起更多
-
相關(guān)疾病:Nephrotic syndrome 2 (NPHS2)
-
亞細(xì)胞定位:[Isoform 1]: Cell membrane; Peripheral membrane protein.; [Isoform 2]: Endoplasmic reticulum.
-
蛋白家族:Band 7/mec-2 family
-
組織特異性:Almost exclusively expressed in the podocytes of fetal and mature kidney glomeruli.
-
數(shù)據(jù)庫(kù)鏈接:
Most popular with customers
-
-
YWHAB Recombinant Monoclonal Antibody
Applications: ELISA, WB, IHC, IF, FC
Species Reactivity: Human, Mouse, Rat
-
Phospho-YAP1 (S127) Recombinant Monoclonal Antibody
Applications: ELISA, WB, IHC
Species Reactivity: Human
-
-
-
-
-